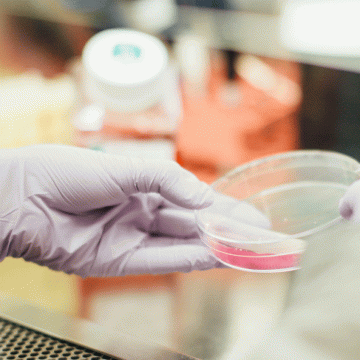
Entwicklung einer Kultivierungsmethode für Prostataorganoide Entwicklung einer Kultivierungsmethode für Prostataorganoide

Heading
PROJEKTE
Mit engagierter Stiftungsarbeit finanzieren wir bedeutende Projekte in der urologischen Forschung.
KOOPERATIONEN
Dabei arbeiten wir eng zusammen mit, auf den Gebiet der Urologie führenden Instituten, Kliniken und Universitäten.
NACHWUCHSTALENTE
Die nächste Wissenschaftsgeneration fördern wir durch Stipendien und Preisgelder für herausragende Leistungen.
DIE STIFTUNG
EIN LEBEN IM DIENST DER MEDIZIN
Die Stiftung Urologische Forschung wurde 1999 von Prof. Dr. med. Stefan A. Loening ins Leben gerufen. Er war nicht nur ein herausragender Mediziner, ausgezeichnet unter anderem mit dem Bundesverdienstkreuz, sondern auch menschlich ein Vorbild für viele. Als Direktor der Klinik für Urologie und Nierentransplantation an der Charité Berlin förderte Professor Loening die Eigenverantwortung seiner Mitarbeiter und schuf ein Klima des kollegialen Miteinanders in einer Zeit, in der dies keinesfalls selbstverständlich war. Die Stiftung steht als Symbol für sein Lebenswerk und seine Vision einer besseren medizinischen Zukunft durch die Förderung und Forderung junger Wissenschaftler.
SCHWERPUNKTE
UROLOGISCHE FORSCHUNG AM PULS DER ZEIT
Die Stiftung Urologische Forschung fördert junge Wissenschaftlerinnen und Wissenschaftler, die sich mit ihren Projekten der Urologie widmen. Dabei steht die Forschung im Bereich der urologischen Krebserkrankungen (Uro-Onkologie) im Vordergrund. Urologische Krebserkrankungen machen knapp ein Viertel der Erstdiagnosen an Krebs in Deutschland aus. Im Zentrum unserer Förderung stehen Projekte in den Bereichen Prostatakarzinom, Harnblasenkarzinom und Nierenkarzinom. Aber auch andere Gebiete der Urologie, wie die Nierentransplantation und Kinderurologie werden gefördert.
AKTUELLE PROJEKTE
STIMMEN AUS DER WISSENSCHAFT
ÜNTERSTÜTZEN SIE UNSERE ARBEIT
Bereits mit kleinen Beträgen können Sie einen Unterschied machen!